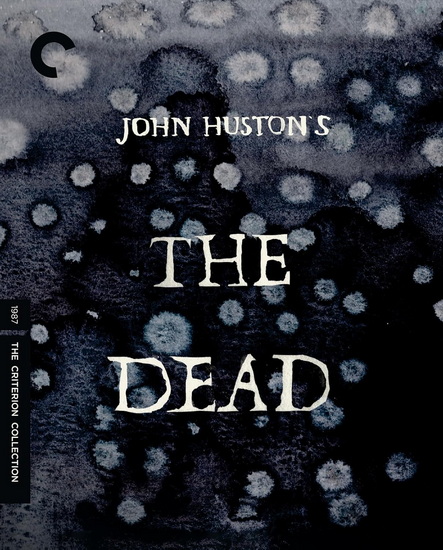
The Dead (1987) (Blu-ray) - JOHN HUSTON

|
|
|
|
|
The Dead (1987) (Blu-ray)
JOHN HUSTON
| 59,99 $
|
|
|
|
 Feuilleter
|
|
|
|
|
|
Ajouter à ma liste de souhaits
|
|
|
The Dead (1987) (Blu-ray)
de
HUSTON, JOHN
| Centre les Rivières |
4225, boulevard des Forges local P13
Trois-Rivières
G8Y 1W2 |
819-376-7227 |
0 |
Heures
d'ouverture |
Pour s'y rendre |
| Chicoutimi |
1120, boulevard Talbot
Chicoutimi
G7H 7R2 |
418-698-1586 |
0 |
Heures
d'ouverture |
Pour s'y rendre |
| St-Romuald |
1238 rue de la Concorde
Saint-Romuald
G6W 0M7 |
418-903-1095 |
0 |
Heures
d'ouverture |
Pour s'y rendre |
| Jean-Talon |
250 Jean Talon Est
Montréal
H2R 1S7 |
438-387-1091 |
0 |
Heures
d'ouverture |
Pour s'y rendre |
| Lebourgneuf |
1580 boul. Lebourgneuf
Québec
G2K 2M4 |
418-380-8118 |
0 |
Heures
d'ouverture |
Pour s'y rendre |
| Place des Arts |
1501 rue Jeanne-Mance
Montréal
H2X 1Z8 |
514-281-0367 |
0 |
Heures
d'ouverture |
Pour s'y rendre |
| Ste-Dorothée |
520, Autoroute Chomedey
Laval
H7X 3S9 |
450-719-2020 |
0 |
Heures
d'ouverture |
Pour s'y rendre |
| Ste-Foy |
2450, boul. Laurier, local M26
Québec
G1V 2L1 |
418-653-2387 |
0 |
Heures
d'ouverture |
Pour s'y rendre |
| Mail Champlain |
2151, boul. La Pinière
Brossard
J4W 2T5 |
450-671-7654 |
0 |
Heures
d'ouverture |
Pour s'y rendre |
| Carrefour Angrignon |
7077, Boul. Newman local 00120
Ville Lasalle
H8N 1X1 |
514-365-2587 |
0 |
Heures
d'ouverture |
Pour s'y rendre |
| Avenue du Parc |
5117, avenue du Parc
Montreal
H2V 4G3 |
514-276-7651 |
0 |
Heures
d'ouverture |
Pour s'y rendre |
| Beauport |
3333 rue du Carrefour local 158
Québec
G1C 5R9 |
581-742-3200 |
0 |
Heures
d'ouverture |
Pour s'y rendre |
| Saint-Bruno |
205 boulevard des Promenades
St-Bruno de Montarville
J3V 5K3 |
450-653-0546 |
0 |
Heures
d'ouverture |
Pour s'y rendre |
| Brossard |
6925, boul. Taschereau
Brossard
J4Z 1A7 |
450-443-5350 |
0 |
Heures
d'ouverture |
Pour s'y rendre |
| Centre Laval |
1600, boul. le Corbusier #109
Laval
H7S 1Y9 |
450-682-2587 |
0 |
Heures
d'ouverture |
Pour s'y rendre |
| Champigny Saint-Denis |
4380, rue St-Denis
Montréal
H2J 2L1 |
514-844-2587 |
0 |
Heures
d'ouverture |
Pour s'y rendre |
| Complexe Desjardins |
C.P. 393 150, rue Ste-Cath.O - local #113
Montréal
H5B 1B5 |
514-288-4844 |
0 |
Heures
d'ouverture |
Pour s'y rendre |
| Vaudreuil-Dorion |
54, Blvd De la Cité des Jeunes Local 100
Vaudreuil-Dorion
J7V 9L5 |
450-218-0571 |
0 |
Heures
d'ouverture |
Pour s'y rendre |
| Plaza St-Hubert |
6255 rue Saint-Hubert
Montréal
H2S 2L9 |
514-288-0952 |
0 |
Heures
d'ouverture |
Pour s'y rendre |
| Boisbriand |
3220 Av. des Grandes Tourelles, Faubourg Boisbriand
Boisbriand, QC
J7H 0A2 |
579-979-6888 |
0 |
Heures
d'ouverture |
Pour s'y rendre |
| Fleury |
1691, rue Fleury Est
Montréal
H2C 1T1 |
514-384-9920 |
0 |
Heures
d'ouverture |
Pour s'y rendre |
| Gatineau |
1100, Boul. Maloney Ouest
Gatineau
J8T 6G3 |
819-243-9700 |
0 |
Heures
d'ouverture |
Pour s'y rendre |
| Place Longueuil |
825 rue Saint-Laurent Ouest Local : 144
Longueuill, QC
J4K 2V1 |
579-881-1402 |
0 |
Heures
d'ouverture |
Pour s'y rendre |
| Granby |
50-2 rue Simonds Nord
Granby
J2J 2L1 |
450-375-0699 |
0 |
Heures
d'ouverture |
Pour s'y rendre |
| Saint-Jérome |
900, boul. Grignon local # 60
St-Jérôme
J7Y 3S7 |
450-432-9100 |
0 |
Heures
d'ouverture |
Pour s'y rendre |
| Pointe-Claire |
6815, Route Transcanadienne, Local C001
Pointe-Claire
H9R 1C4 |
514-782-1222 |
0 |
Heures
d'ouverture |
Pour s'y rendre |
| Rosemère |
382 boul. Labelle
Rosemère
J7A 3R8 |
450-434-0202 |
0 |
Heures
d'ouverture |
Pour s'y rendre |
| Carrefour Laval |
3035 Boulevard Le Carrefour Local SR24B
Laval
H7T 1C8 |
450-681-3032 |
0 |
Heures
d'ouverture |
Pour s'y rendre |
| Drummondville |
520 boul Saint-Joseph
Drummondville
J2C 2B8 |
819-850-2000 |
0 |
Heures
d'ouverture |
Pour s'y rendre |
| St-Georges de Beauce |
8540, Boulevard Lacroix
St-Georges de Beauce
G5Y 2B5 |
418-227-3182 |
0 |
Heures
d'ouverture |
Pour s'y rendre |
| Côte-des-Neiges |
5252, chemin Côte-des-Neiges
Montréal
H3T 1X8 |
514-342-1515 |
0 |
Heures
d'ouverture |
Pour s'y rendre |
| Repentigny |
100 Boul. Brien Ouest, local 158b
Repentigny
J6A 5N4 |
450-932-6892 |
0 |
Heures
d'ouverture |
Pour s'y rendre |
| Trois-Rivières |
3275, Boul des Récollets
Trois-Rivières
G9A 6M1 |
819-840-2624 |
0 |
Heures
d'ouverture |
Pour s'y rendre |
| Centre Rockland |
2305 Chemin Rockland
Mont-Royal
H3P 3E9 |
514-543-5221 |
0 |
Heures
d'ouverture |
Pour s'y rendre |
| Place du Royaume |
1401 boulevard Talbot local #170
Chicoutimi
G7H 5N6 |
581-654-1127 |
0 |
Heures
d'ouverture |
Pour s'y rendre |
| Carrefour l'Estrie |
3050, boul. Portland - local N-11
Sherbrooke
J1L 1K1 |
819-569-9957 |
0 |
Heures
d'ouverture |
Pour s'y rendre |
| St-Jean-sur-Richelieu |
927 Boulevard Séminaire Nord
Montréal
J3A 1B5 |
579-381-1110 |
0 |
Non
disponible |
|
| Sorel |
450, boul. Poliquin - Local 102
Sorel
J3P 7R5 |
450-746-8771 |
0 |
Heures
d'ouverture |
Pour s'y rendre |
| Les Galeries de Terrebonne |
1185, boul. Moody Local 081
Terrebonne
J6W 3Z5 |
450-492-1011 |
0 |
Heures
d'ouverture |
Pour s'y rendre |
| Lévis |
1200 Alphonse-Desjardins #0120
Lévis
G6V 6Y8 |
418-837-5538 |
0 |
Heures
d'ouverture |
Pour s'y rendre |
| Galeries d Anjou |
7999, boul. Les Galeries d'Anjou
Ville d'Anjou
H1M 1W6 |
514-353-2353 |
0 |
Heures
d'ouverture |
Pour s'y rendre |
| Victoriaville |
1111, boul. Jutras Est - Local 1
Victoriaville
G6S 1C1 |
819-357-4878 |
0 |
Heures
d'ouverture |
Pour s'y rendre |
| Place Ville Marie |
1 Place Ville-Marie, local 11170
Montréal, QC
H3B 2C4 |
514-552-9649 |
0 |
Heures
d'ouverture |
Pour s'y rendre |
|
|
|
|
EN SAVOIR PLUS
Résumé
*** Résumé en anglais seulement ***
The elegiac last film by John Huston finds the legendary director adapting a masterly short story by his favorite writer, James Joyce, into a poignant reflection on the totality of life. During a snowy winter in turn-of-the-twentieth-century Dublin, the members of an extended family convene for a night of wine, song, and celebration—but it’s not until after the festivities that Gretta (Anjelica Huston) reveals a secret to her husband (Donal McCann) that casts the entire evening in a new light. Aglow with a mix of nostalgia and melancholy, and featuring a cast of stellar Irish actors, The Dead gracefully evokes the passage of time and the haunting power of memory.
Détails
|
Prix :
|
59,99 $
|
|
Catégorie :
|
|
|
Auteur :
|
JOHN HUSTON
|
|
Titre :
|
The Dead (1987) (Blu-ray)
|
|
Date de parution :
|
janvier 2026
|
|
|
|
|
|
Éditeur :
|
CRITERION
|
|
|
|
|
|
Sujet :
|
FILM DRAME
|
|
UPC :
|
715515327114
|
|
Référence Renaud-Bray :
|
22074231
|
|
|
|
No de produit :
|
4552490
|
The Dead (1987) (Blu-ray)
,
HUSTON, JOHN
©
CRITERION
2026
|
|
1449 article(s) au panier.
Renaud-Bray vous offre
les frais de livraison *
|